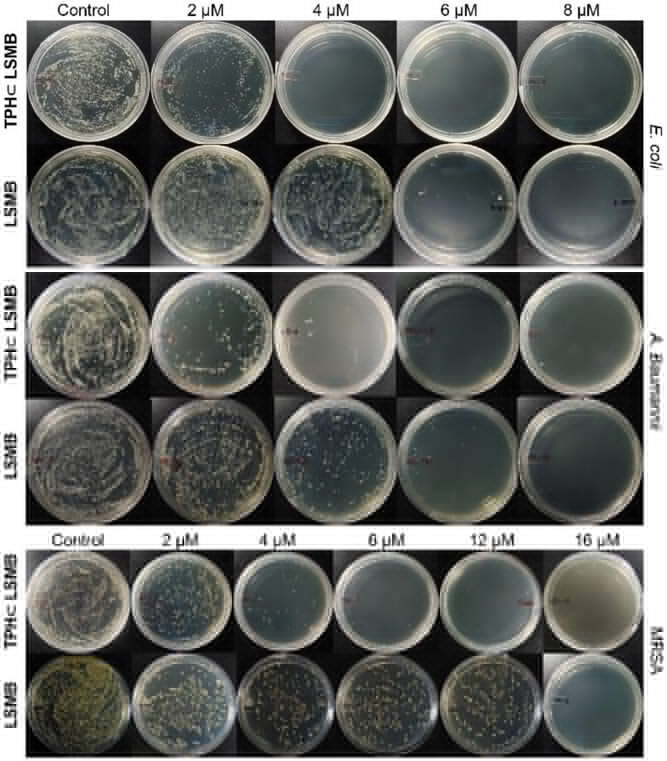
image.png

【Angew.Chem.】460 倍强效!新型荧光系统攻克耐药革兰氏阴性菌
✨文章标题:Dual-Function Antibacterial and Antibiofilm Agent Based on a Confinement-Activated Fluorescent System in Water ✉️作者:Prof.Dr. Mrinmoy De, Prof.Dr. Partha Sarathi Mukherjee 等 🔗链接:https://doi.org/10.1002/anie.202521285

你可能没意识到,一场无声的 “抗药战争” 正在全球蔓延。当我们感冒发烧依赖抗生素退烧时,细菌早已在悄悄进化 —— 滥用抗生素导致的多重耐药性(MDR),正让曾经的 “救命药” 逐渐失效。更可怕的是,革兰氏阴性菌这类 “硬核反派”,凭借外层富含脂多糖(LPS)的双层膜结构,像穿了 “纳米防弹衣”,让多数抗生素难以穿透,成为慢性感染、医院交叉感染的主要元凶。
世界卫生组织预警,若不及时研发新型抗菌药物,到 2050 年,全球每年将有 1000 万人死于耐药菌感染,远超当前癌症死亡人数。而传统小分子抗生素的研发周期长达 10 年以上,且极易被细菌的外排泵 “泵出” 细胞,对革兰氏阴性菌的治疗效果越来越差。
就在这一困境下,印度科学理工学院的研究团队带来了突破性进展 —— 他们研发出一种 “可编程纳米分子桶”(LSMB),通过主客体自组装技术,将荧光分子 TPH 封装其中,形成的 TPH⊂LSMB 复合物,抗菌活性比万古霉素强 460 倍,比环丙沙星强 380 倍,尤其对革兰氏阴性菌展现出 “精准打击” 能力,且无需依赖强光激活,为解决耐药菌危机提供了全新思路。
核心技术:“纳米笼子 + 荧光 guest” 的协同抗菌魔法

一、定制化 “分子桶”:专为疏水分子打造的 “纳米住宅”
要理解这项技术的核心,首先得搞懂 “分子桶” LSMB 是什么。你可以把它想象成一个用金属和有机配体 “乐高” 拼出来的纳米笼子,尺寸只有约 12.68×12.68×12.75 ų,刚好能装下特定的疏水分子。
这个 “笼子” 的搭建过程很巧妙:研究团队先设计了一种低对称性配体 L(含两种不同的供体基团),再让它与 90° 顺式受阻的 Pd (II) 受体(相当于 “乐高连接件”)按 2:1 的摩尔比,在 60℃的 DMSO 溶液中自组装。就像拼图自动找到匹配的凹槽,配体和金属受体通过配位键形成稳定的四面部分子桶,最终呈现 D₂d 对称性的管状结构,两端有开放的 “窗口”,内部是疏水空腔。
更关键的是,这个 “分子桶” 是水溶性的。通过搭配合适的反离子,它能在水溶液中稳定存在,这就解决了很多疏水抗菌分子 “难溶于水、无法发挥作用” 的痛点 —— 毕竟生物体内的环境主要是水溶液,水溶性是生物医用材料的 “入门必备”。

二、荧光 guest 的 “变身记”:从 “沉默” 到 “强效发光 + 抗菌”
“分子桶” 本身有一定抗菌活性,但真正的 “战斗力” 来自于它的 “房客”——TPH 分子 [1,4 - 双 (2,2 - 二苯基乙烯基) 苯]。TPH 是一种 AIEgen(聚集诱导发光材料),但它在稀溶液中几乎不发光,就像一个 “沉默的战士”,只有聚集起来才会展现荧光特性。
而 “分子桶” LSMB 恰好提供了一个完美的 “激活环境”:当 TPH 被封装进 LSMB 的疏水空腔后,空间限制让 TPH 的分子内运动被牢牢锁住 —— 这就像一个原本好动的孩子被放进定制的小座椅,无法随意扭动,能量不会通过分子运动消耗,从而实现了 “ confinement - activated 荧光增强”。
实验数据显示,在 10⁻⁵ M 的稀水溶液中,TPH⊂LSMB 的荧光强度是纯 TPH 四氢呋喃溶液的 17 倍,是 TPH 在 90% 水 - 四氢呋喃混合液中聚集态的 1.4 倍,荧光量子产率高达 62.5%。更重要的是,这种 “封装效应” 不仅激活了荧光,还让 TPH 和 LSMB 形成协同抗菌作用,比单独的 LSMB 战斗力翻倍。

三、革兰氏阴性菌的 “专属克星”:电荷匹配 + 结构渗透
为什么这个 “分子桶复合物” 对革兰氏阴性菌特别有效?关键在于 “电荷互补” 和 “结构适配”。革兰氏阴性菌的外膜富含带负电的脂多糖(LPS),而 LSMB 分子桶本身带有正电荷,就像磁铁的异极相吸,让分子桶能快速吸附在细菌表面。
相比之下,革兰氏阳性菌只有一层厚厚的肽聚糖细胞壁,没有外层负电膜,与分子桶的静电相互作用较弱,所以 TPH⊂LSMB 对革兰氏阴性菌的抗菌活性更突出 —— 对鲍曼不动杆菌(A. baumannii)的最低杀菌浓度(MBC)仅 4μM(光照下),对大肠杆菌(E. coli)也是 4μM,而对 MRSA(耐甲氧西林金黄色葡萄球菌)是 6μM,展现出明确的选择性。
这种选择性是前所未有的:传统抗生素要么 “广谱杀菌” 不分好坏,要么对革兰氏阴性菌束手无策,而 TPH⊂LSMB 精准瞄准耐药性更强的革兰氏阴性菌,既能提高治疗效率,又能减少对肠道有益菌的破坏。

数据解读:460 倍增效背后,是全方位的性能碾压
一、抗菌活性:比传统抗生素强两个数量级
衡量抗菌药物效果的核心指标是 “最低杀菌浓度(MBC)”—— 即能彻底杀死细菌的最低浓度,数值越低,效果越强。
根据实验数据,在光照条件下,TPH⊂LSMB 对 MRSA 的 MBC 仅为 6μM,而临床常用的万古霉素对 MRSA 的 MBC 超过 2.76mM(相当于 2760μM),前者的抗菌活性是后者的 460 倍以上;对大肠杆菌,TPH⊂LSMB 的 MBC 是 4μM,环丙沙星的 MBC 约 1.5mM(1500μM),增效达 375 倍。
即使在黑暗条件下,TPH⊂LSMB 的表现依然出色:对鲍曼不动杆菌和大肠杆菌的 MBC 都是 6μM,对 MRSA 是 12μM,而单独的 LSMB 对 MRSA 的 MBC 是 16μM,说明 TPH 的加入显著提升了抗菌效果。更值得注意的是,配体 L 的水溶性衍生物(L-Modified)在 50μM 浓度下才展现中等抗菌活性,Pd (II) 受体则几乎无活性,证明抗菌效果来自主客体复合物的协同作用,而非单一成分。

二、抗生物膜能力:瓦解细菌的 “防护堡垒”
慢性感染的关键难题是细菌形成的 “生物膜”—— 细菌聚集在 extracellular polymeric substance(EPS)基质中,就像建成了一座 “防御堡垒”,让抗生素无法渗透,导致感染反复发作。
研究团队通过 MTT 法(检测细胞活力)和结晶紫染色法(检测生物膜 biomass),测试了 TPH⊂LSMB 的抗生物膜活性。结果显示,在光照条件下,TPH⊂LSMB 能显著降低大肠杆菌和 MRSA 生物膜的活力,对大肠杆菌生物膜的 biomass 抑制效果更突出 —— 这得益于它对革兰氏阴性菌的选择性吸附和渗透能力。
荧光成像显示,经 TPH⊂LSMB 处理后,生物膜结构被严重破坏,残留的活菌数量大幅减少;而 LSMB 处理组的生物膜破坏程度明显较轻。更重要的是,TPH⊂LSMB 在黑暗中也能发挥抗生物膜作用,只是光照下效果更优,这意味着它不仅能用于体表感染(可接触光照),也能用于体内深层感染(无需依赖外部光源)。
三、作用机制:三重打击,让细菌 “无处可逃”
为什么 TPH⊂LSMB 的杀菌效果如此强悍?研究团队通过一系列实验揭示了其三重作用机制,层层递进瓦解细菌防御:
第一重是 “膜去极化”:细菌细胞膜的正常电位是维持生命活动的关键,TPH⊂LSMB 的正电荷与细菌膜的负电荷相互作用,导致膜电位紊乱(用 DISC3 (5) 荧光探针检测到荧光增强)。这就像给细菌的 “电力系统” 断了电,使其无法正常代谢。
第二重是 “膜破裂”:通过 ONPG assay 检测到,TPH⊂LSMB 处理后,细菌释放出大量 β- 半乳糖苷酶(β-gal),说明细胞膜被破坏,细胞内容物外泄。扫描电子显微镜(SEM)图像直观显示, untreated 的细菌细胞膜完整光滑,而经 TPH⊂LSMB 处理后,细菌表面出现明显破损、皱缩,甚至裂解。
第三重是 “intracellular ROS 生成”:TPH⊂LSMB 被细菌内化后,会产生大量活性氧(ROS),主要是单线态氧(¹O₂)—— 通过 DCFDA 荧光探针检测到,大肠杆菌体内的 ROS 水平是 MRSA 的 25 倍,这也解释了为什么它对革兰氏阴性菌更有效。ROS 会破坏细菌的 DNA、蛋白质等生物大分子,最终导致细菌死亡。
这三重机制协同作用,既破坏细菌的外部防御(细胞膜),又攻击内部核心(生物大分子),让细菌难以产生耐药性 —— 毕竟同时对抗三种作用机制,远比对抗单一靶点(如传统抗生素的抑制细胞壁合成)难得多。

四、生物相容性:安全无毒,符合医用标准
一款抗菌药物要走向临床,生物相容性是关键。研究团队通过溶血 assay 和细胞毒性 assay 测试了 TPH⊂LSMB 的安全性:
在溶血 assay 中,TPH⊂LSMB 在黑暗条件下浓度高达 30μM 时,溶血率依然极低;光照条件下 10μM 浓度内无溶血现象,说明它对红细胞几乎无损伤,不会引发溶血副作用。
在细胞毒性 assay 中,用人类胚胎肾细胞(HEK 293)测试发现,TPH⊂LSMB 在 30μM 浓度内(无论黑暗还是光照),细胞存活率都很高,无明显细胞毒性。
对比其抗菌浓度(MBC 低至 4μM),TPH⊂LSMB 的 “治疗窗口” 很大 —— 即有效治疗浓度远低于有毒浓度,这为其临床应用奠定了基础。

收尾:应用前景、局限性与未来方向
一、应用场景:从伤口愈合到慢性感染治疗
TPH⊂LSMB 的独特优势,让它在多个领域拥有广阔应用前景:
首先是体表伤口感染治疗:比如糖尿病足溃疡、烧伤感染等,这些部位常被革兰氏阴性菌感染,且易形成生物膜,TPH⊂LSMB 可制成药膏或敷料,光照下能快速杀菌,黑暗中也能发挥作用,加速伤口愈合。
其次是废水处理:工业废水和医疗废水中含有大量耐药菌,TPH⊂LSMB 可用于水处理系统,高效杀灭水中的革兰氏阴性菌,减少耐药基因传播。
再者是慢性感染治疗:如肺炎、尿路感染等由革兰氏阴性菌引起的慢性感染,传统抗生素治疗效果差,TPH⊂LSMB 的三重杀菌机制能有效瓦解生物膜,解决感染复发问题。
此外,它还可用于医疗器械消毒:导尿管、呼吸机等医疗器械易滋生耐药菌生物膜,用 TPH⊂LSMB 处理后,能降低交叉感染风险。
二、局限性:通往临床的 “拦路虎”
尽管表现出色,TPH⊂LSMB 仍有需要改进的地方。研究团队也客观指出,目前它更适合局部应用(如伤口敷料),若要用于静脉注射治疗全身性感染,还需解决三个关键问题:一是血清稳定性,血液中的蛋白质可能会影响分子桶的结构;二是网状内皮系统(RES)的快速摄取,可能导致药物在肝脏、脾脏聚集,降低疗效;三是深层组织的光照传递,虽然黑暗中也有活性,但光照能增强效果,如何让深层感染部位获得足够光照仍需探索。
另外,目前的研究主要在体外和细胞层面进行,还需要进一步的动物实验和临床试验,验证其在体内的安全性和有效性。
三、未来方向:从 “局部有效” 到 “全身可用”
针对这些局限性,研究团队规划了未来的研究重点:一是优化分子桶的表面修饰,比如添加 “隐形涂层”,避免被 RES 摄取,提高血清稳定性,打造适合静脉注射的配方;二是深入研究其在动物体内的药代动力学和生物分布,明确最佳给药剂量和方式;三是开发可靶向特定感染部位的版本,比如在分子桶表面连接细菌特异性配体,进一步提升选择性;四是探索与其他抗菌药物的联合使用,形成 “协同疗法”,应对更复杂的耐药菌感染。
从长远来看,这项技术的核心价值不仅在于开发出一款新型抗菌药物,更在于提供了一种 “可编程主客体复合物” 的设计思路 —— 通过调整分子桶的尺寸、电荷和配体结构,有望定制出针对不同耐药菌的 “专属纳米武器”,彻底改变抗生素研发的 “单一靶点” 模式,为解决全球耐药菌危机开辟一条全新路径。
结语:在抗生素耐药性日益严峻的今天,TPH⊂LSMB 的出现就像一束光。它以 460 倍于传统抗生素的强效、对革兰氏阴性菌的精准打击、安全无毒的生物相容性,展现出成为下一代抗菌药物的巨大潜力。虽然距离临床应用还有一段路要走,但这项研究让我们看到,通过 supramolecular 化学的创新,人类完全有能力攻克耐药菌这个 “医学难题”,未来或许再也不用为 “无药可用” 而担忧。